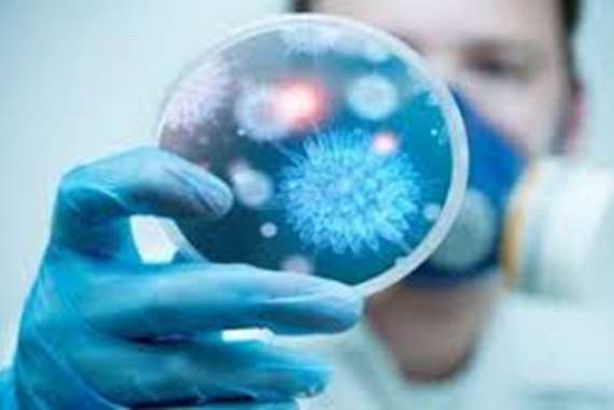
فيروس" كورونا"

الثلاثاء، 04-02-2020
11:10 م
المصريون ووكالات
علّقت إندونيسيا بشكل مؤقت، الثلاثاء، استيراد حيوانات حية من الصين، بسبب تفشي "فيروس كورونا".
وأعلن وزير الشؤون الاقتصادية إيرلانغا هارتارتو، تعليق بلاده بشكل مؤقت استيراد حيوانات حية من الصين، بسبب تفشي "فيروس كورونا"، بحسب ما أفادت صحيفة "كومباس" الإندونيسية، الثلاثاء.
وأضاف هارتارتو، أن بلاده ستعيد إلى الصين حيوانات حية استوردتها منها خلال الفترات الأخيرة.
ولفت إلى أن بلاده لن تفرض أي قيود على استيراد الخضار والفاكهة من الصين، بسبب عدم مساهمتها في نقل الفيروس.
وأوضح الوزير، أن جاكرتا ستتابع عن كثب مدى انتشار الفيروس، لغاية منتصف فبراير/ شباط الجاري.
وفي وقت سابق الثلاثاء، أورد التقرير اليومي للجنة الوطنية للصحة بالصين، ارتفاع عدد ضحايا فيروس "كورونا المستجد" محليا، إلى 425 حالة وفاة، و20 ألفا و438 إصابة مؤكدة.
ووفق التقرير الصيني ذاته، فإن ألفين و788 من المصابين في "حالة حرجة"، بينما يشتبه في إصابة 23 ألفا و214 شخصا بالفيروس.
فيما سجلت 25 دولة أخرى 165 إصابة مؤكدة بالفيروس، بجانب تسجيل حالتي وفاة فقط خارج البر الصيني، الأولى في الفلبين، والثانية في مقاطعة هونغ كونغ التابعة إداريا للصين.
وفيروس "كورونا الجديد" ظهر في ديسمبر/ كانون الأول 2019، في سوق بولاية ووهان الصينية ، لينتشر عبر العالم. -